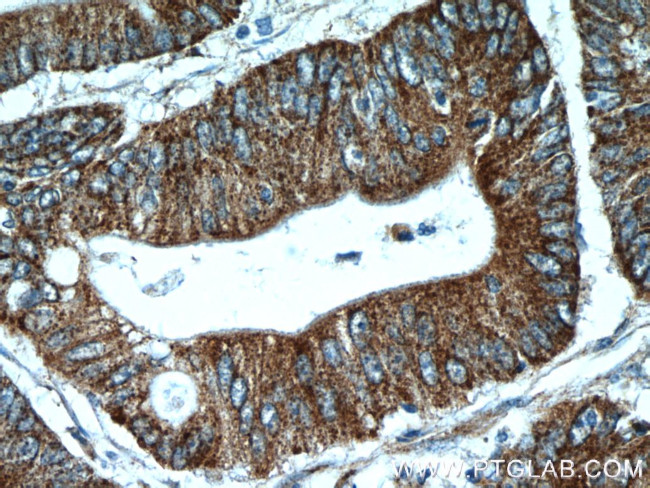
EB1 Antibody in Immunohistochemistry (Paraffin) (IHC (P))

Search
Proteintech
EB1 Polyclonal Antibody
{{$productOrderCtrl.translations['antibody.pdp.commerceCard.promotion.promotions']}}
{{$productOrderCtrl.translations['antibody.pdp.commerceCard.promotion.viewpromo']}}
{{$productOrderCtrl.translations['antibody.pdp.commerceCard.promotion.promocode']}}: {{promo.promoCode}} {{promo.promoTitle}} {{promo.promoDescription}}. {{$productOrderCtrl.translations['antibody.pdp.commerceCard.promotion.learnmore']}}
产品信息
17717-1-AP
种属反应
宿主/亚型
分类
类型
抗原
偶联物
形式
浓度
规格
纯化类型
保存液
内含物
保存条件
运输条件
产品详细信息
Immunogen sequence: MAVNVYSTS VTSDNLSRHD MLAWINESLQ LNLTKIEQLC SGAAYCQFMD MLFPGSIALK KVKFQAKLEH EYIQNFKILQ AGFKRMGVDK IIPVDKLVKG KFQDNFEFVQ WFKKFFDANY DGKDYDPVAA RQGQETAVAP SLVAPALNKP KKPLTSSSAA PQRPISTQRT AAAPKAGPGV VRKNPGVGNG DDEAAELMQQ VNVLKLTVED LEKERDFYFG KLRNIELICQ ENEGENDPVL QRIVDILYAT DEGFVIPDEG GPQEEQEEY (1-268 aa encoded by BC106068 )
靶标信息
EB1 family proteins are evolutionarily conserved proteins that bind microtubule plus-ends and centrosomes and regulate the dynamics and organization of microtubules. The MAPRE genes encode the EB1 family proteins. The human MAPRE genes MAPRE1, MAPRE2, and MAPRE3 code for EB1, RP1, and EBF3 proteins, respectively. EB1 family members appear to be expressed ubiquitously. The EB1 (MAPRE1) gene, at 20q11. 2, is fused to MLL in an adult patient with pro-B acute lymphoblastic leukemia. EB1 is a microtubule-associated protein that interacts with the colorectal adenomatous polyposis coli tumor-suppressor protein and plays important roles in regulating microtubule dynamics, cell polarity, and chromosome stability.
仅用于科研。不用于诊断过程。未经明确授权不得转售。
生物信息学
蛋白别名: adenomatosis polyposis coli binding protein Eb1; adenomatous polyposis coli-binding protein EB1; APC-binding protein EB1; EB1; End-binding protein 1; MGC117374; MGC129946; Microtubule-associated protein RP/EB family member 1; unnamed protein product
基因别名: 5530600P05Rik; AI462499; AI504412; AW260097; BIM1p; D2Ertd459e; EB1; MAPRE1
UniProt ID: (Human) Q15691, (Mouse) Q61166
Entrez Gene ID: (Human) 22919, (Mouse) 13589